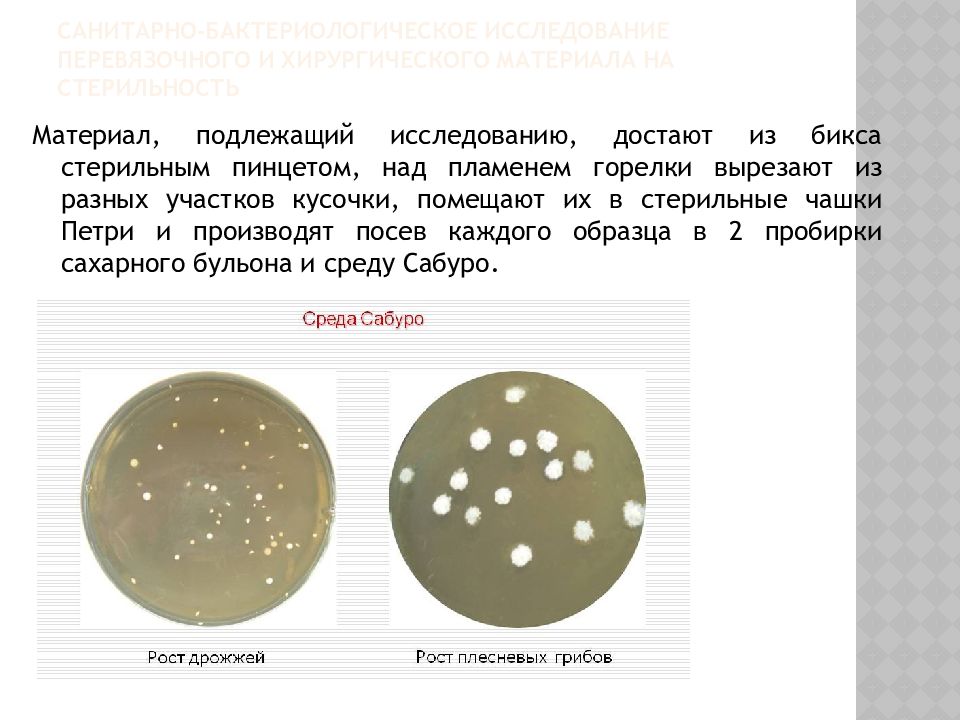
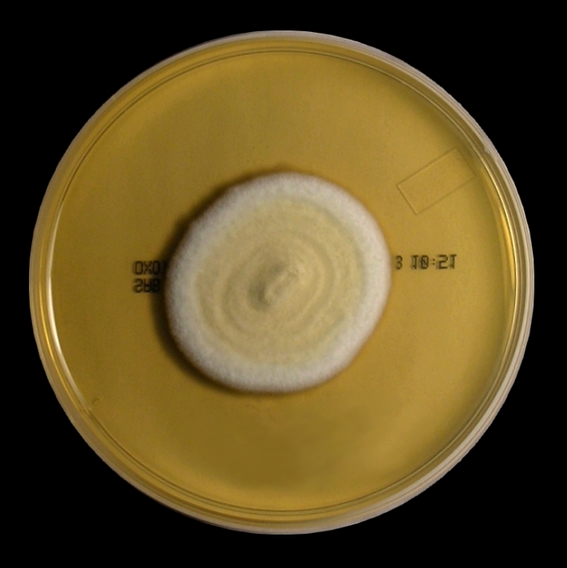

Среда 2 сабуро
Розовый герой это
Group j k
Скоро будем екатеринбург
Характеристика темы из рассказа
График намаза июль
Тг канал ответы огэ 2025
Последствия перевод на английский
Гибель 30 полка под волчанском
Как сложить печь своими руками пошаговая
More ore tools
Аудиокниги фэнтези галины гончаровой
Принимают ли в стамбуле старые доллары
Тревожность причины как избавиться
Среда 2 сабуро 153 фото